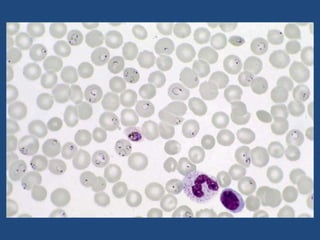

Malaria is a mosquito-borne infectious disease caused by Plasmodium parasites. It is transmitted through the bites of infected Anopheles mosquitoes. The malaria parasite has a complex life cycle involving a mosquito vector and a human host. Symptoms include cyclic fever, chills, and sweats. Diagnosis is made by blood smear examination. Treatment depends on the Plasmodium species and includes antimalarial drugs like chloroquine, quinine, and artemisinin combinations. Supportive care and chemoprophylaxis are also important aspects of malaria management.